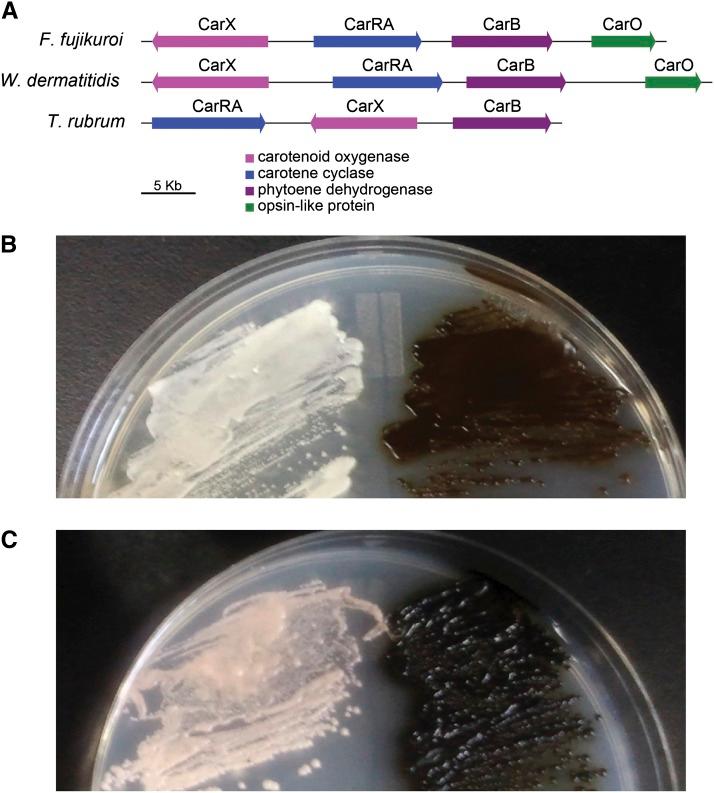
https://cdn.ncbi.nlm.nih.gov/pmc/blobs/2559/4059230/c1361f78b7ad/561f6.jpg

汪氏外瓶霉的比较基因组和转录组分析,该菌是暗色丝孢霉病的主要致病菌,也是一种模式黑酵母人类病原体。
Comparative genomic and transcriptomic analysis of wangiella dermatitidis, a major cause of phaeohyphomycosis and a model black yeast human pathogen.
机构信息
Broad Institute of Massachusetts Institute of Technology and Harvard, Cambridge, Massachusetts 02142.
出版信息
G3 (Bethesda). 2014 Apr 16;4(4):561-78. doi: 10.1534/g3.113.009241.
Black or dark brown (phaeoid) fungi cause cutaneous, subcutaneous, and systemic infections in humans. Black fungi thrive in stressful conditions such as intense light, high radiation, and very low pH. Wangiella (Exophiala) dermatitidis is arguably the most studied phaeoid fungal pathogen of humans. Here, we report our comparative analysis of the genome of W. dermatitidis and the transcriptional response to low pH stress. This revealed that W. dermatitidis has lost the ability to synthesize alpha-glucan, a cell wall compound many pathogenic fungi use to evade the host immune system. In contrast, W. dermatitidis contains a similar profile of chitin synthase genes as related fungi and strongly induces genes involved in cell wall synthesis in response to pH stress. The large portfolio of transporters may provide W. dermatitidis with an enhanced ability to remove harmful products as well as to survive on diverse nutrient sources. The genome encodes three independent pathways for producing melanin, an ability linked to pathogenesis; these are active during pH stress, potentially to produce a barrier to accumulated oxidative damage that might occur under stress conditions. In addition, a full set of fungal light-sensing genes is present, including as part of a carotenoid biosynthesis gene cluster. Finally, we identify a two-gene cluster involved in nucleotide sugar metabolism conserved with a subset of fungi and characterize a horizontal transfer event of this cluster between fungi and algal viruses. This work reveals how W. dermatitidis has adapted to stress and survives in diverse environments, including during human infections.
黑或深褐色(暗色)真菌可引起人类皮肤、皮下和全身感染。暗色真菌在强光、高辐射和极低 pH 值等应激条件下茁壮成长。Wangiella(Exophiala)dermatitidis 可以说是研究得最多的人类暗色真菌病原体。在这里,我们报告了我们对 W. dermatitidis 基因组和对低 pH 应激的转录反应的比较分析。这表明,W. dermatitidis 丧失了合成α-葡聚糖的能力,而α-葡聚糖是许多致病性真菌用来逃避宿主免疫系统的细胞壁化合物。相比之下,W. dermatitidis 与相关真菌具有相似的几丁质合酶基因谱,并强烈诱导细胞应对 pH 应激时细胞壁合成相关基因的表达。大量的转运蛋白可能使 W. dermatitidis 具有更强的能力来去除有害产物,并在各种营养源上生存。基因组编码了三种独立的黑色素生成途径,这一能力与发病机制有关;这些途径在 pH 应激期间活跃,可能产生屏障以防止应激条件下可能发生的累积氧化损伤。此外,还存在一整套真菌感光基因,包括类胡萝卜素生物合成基因簇的一部分。最后,我们确定了一个与真菌子集保守的涉及核苷酸糖代谢的双基因簇,并对该簇在真菌和藻类病毒之间的水平转移事件进行了特征描述。这项工作揭示了 W. dermatitidis 是如何适应应激并在各种环境中生存的,包括在人类感染期间。